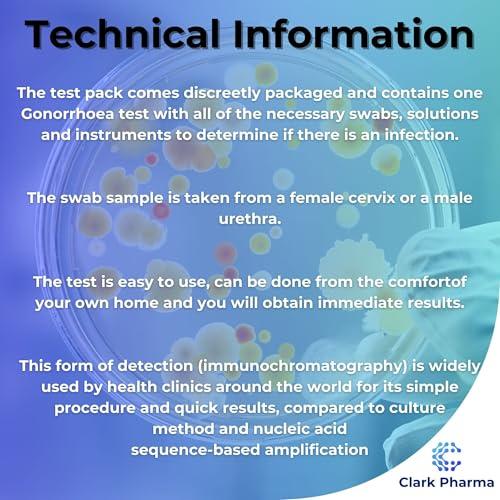
Clark Pharma Gonorrhoea Test Kit | Tests Male (Urethral Swab) or Female (Cervical Swab) for Gonorrhoea Bacteria | Rapid STD STI Test (Gonorrhoea Only)

Description
- RAPID - This test can be performed in less than 5 minutes
- EASY - Simply swab the infected area, mix with the diluents and add to the test cassette
- DISCREET PACKAGING
- PROFESSIONAL & ACCURATE - This very same test method is used by professional health clinics worldwide. If the test is carried out correctly, the accuracy rate is over 99.9%.
- SAFETY - CE marked and the reactive test cassettes are individually wrapped to remain sterile and prevent contamination
This test pack contains a Gonorrhoea Test which is a swab test. The female cervix or male urethra must be swabbed to collect the sexually transmitted infection. The swab is then mixed with two diluents and added to a test cassette and a result of positive, negative or invalid will be displayed within seconds.